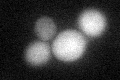
YLR245C
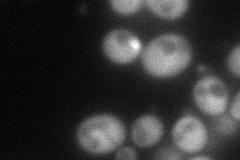
YLR245C
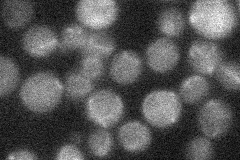
YLR245C
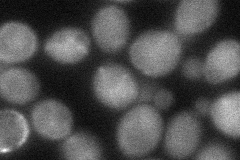
YLR245C
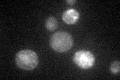
YLR245C

View description
Cytidine deaminase; catalyzes the modification of cytidine to uridine in vitro but native RNA substrates have not been identified, localizes to both the nucleus and cytoplasm
Localization:
Intensity:
Fold change:
Significance:
-
C’ GFP library in SD
cytosol33.92 -
N' NOP1pr-GFP in SD
cytosol91.3576 -
N' TEF2pr-mCherry in SD

cytosol172.122 -
N' NATIVEpr-GFP in SD
below threshold22.079 -
N' TEF2pr-VC and Cyto-VN in SD
cytosol44.6056 -
C’ GFP library in SD+DTT

cytosol26.970.79No -
C’ GFP library in SD+H2O2

cytosolN/AN/ANo -
C’ GFP library in Starvation Media
cytosol48.131.41Yes -
C’ GFP library on the background of Pup2-DaMP

cytosol -
C’ GFP library on the background of CCT mutant

cytosolN/AN/ANo
